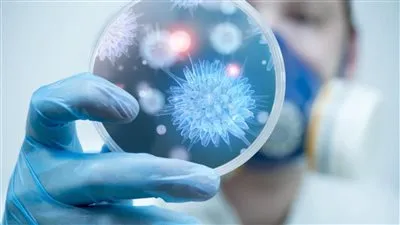
اكتشاف جديد يقضى على السرطان

عاجل
أنفيلد يشهد قمة حماسية.. متابعة حية لمواجهة ليفربول وليدز يونايتد بالدوري الإنجليزي
أنفيلد على موعد مع الإثارة.. متابعة حية لمواجهة ليفربول وليدز يونايتد في الدوري الإنجليزي
قمة أنفيلد تشعل الجولة 19.. موعد مباراة ليفربول وليدز يونايتد والقنوات الناقلة بث مباشر
الزمالك يصطدم بالاتحاد السكندري في مواجهة حاسمة بكأس الرابطة.. بث مباشر لحظة بلحظة
شاهد الآن بث مباشر الزمالك أمام الاتحاد السكندري في كأس عاصمة مصر.. صراع التأهل يشتعل في برج العرب